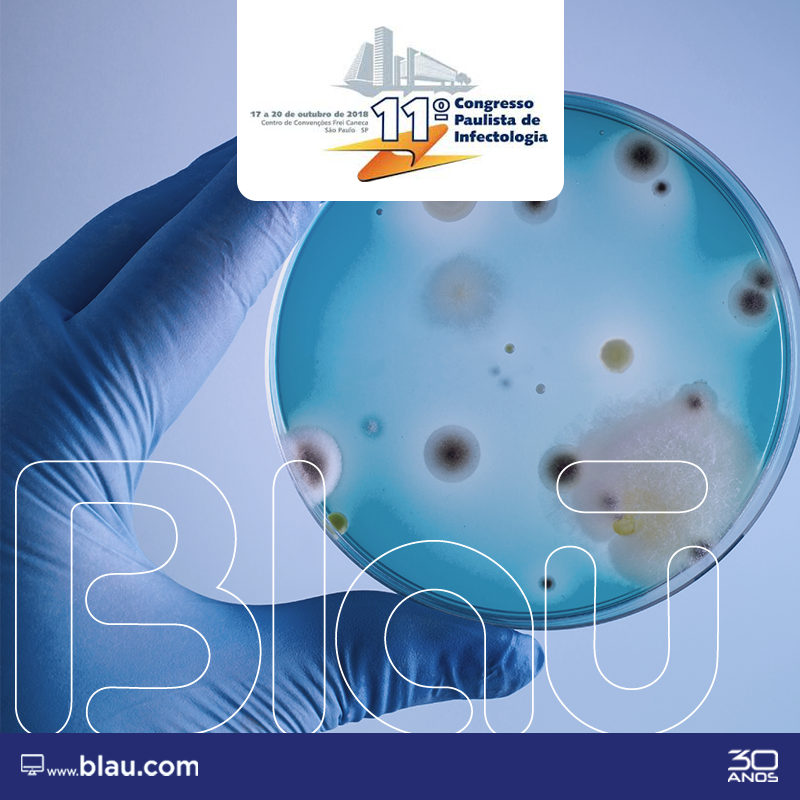

A Blau participará do 11º Congresso Paulista de Infectologia, que acontecerá na cidade de São Paulo.
A Infectologia congrega médicos que estão inseridos em diferentes campos da assistência à saúde, podendo contribuir atualmente nas áreas hospitalar e clínica, na vigilância em saúde, no diagnóstico e no enfrentamento das epidemias, no estudo das doenças emergentes e reemergentes, entre outras frentes infecciosas.
11º Congresso Paulista de Infectologia (17 a 20/10)
Estande nº 8
Local do Evento: Centro de Convenções Frei Caneca – SP – 5º Pavimento
Rua Frei Caneca, 569 – Consolação – São Paulo – SP